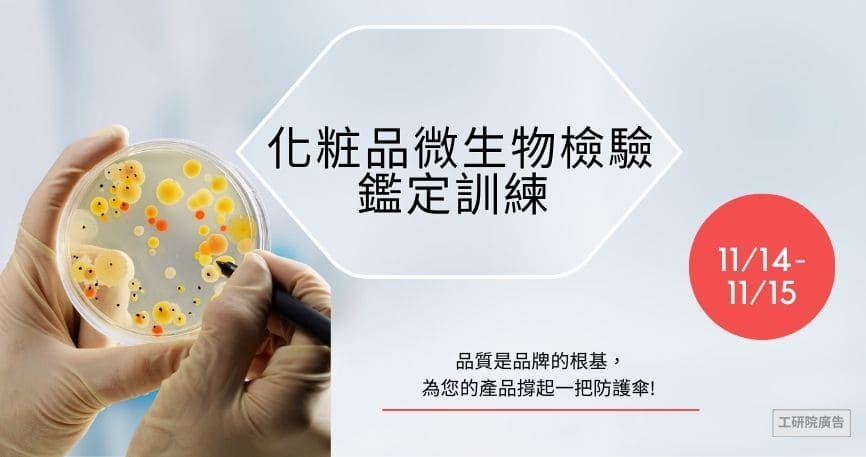

主編精選
機電整合暨可程式邏輯控制器(PLC)研習班
臺北、實體/線上
預防及杜絕生產製程與品管研發的缺失與損失-防呆法的活用與實務
混成
機械材料試驗與破損分析實務培訓班
臺北、實體
Vibe Coding × AI程式開發-進階實戰班(規格驅動開發與AI協作)
新竹/實體
數位自學
生成式AI浪潮來臨,跨域創新應用爆發,集結產業專家融合工研院各所技術,針對人工智慧、資訊、通訊三大次領域,規劃包括:資料分析、資訊安全、自駕車、5G NR及射頻…等核心課程,期能充裕國內資訊人才,接軌國際。
高深寬比填孔電鍍技術於PCB、半導體產業之應用
數位通訊原理
資通安全通識教育訓練雲端自學課程
不寫程式也能玩資料分析2-orange data mining
【數位自學】自駕車的關鍵技術與應用
先進駕駛輔助系統之影像感知技術
針對智慧製造相關專業與技術之人才需求,融合工研院機械所、智機中心技術,從低碳製造、機器人、機電整合、電動車機電核心等面向規畫系列課程,包括電動車核心技術整合與應用系列、機電整合技術與人機系統系列、智慧生產技術及製程管理系列 、製程品質管制結合數據分析應用系列、AMR 自主移動機器人系列…等學程,引領企業打造智慧綠色製造生態系, 邁向綠色經濟。
精密控制與無人機技術課程
智慧工廠系統整合技術應用學程
MSA量測系統分析
智慧工廠系統整合技術應用學程
智慧工廠系統整合技術應用學程
因應新冠疫情爆發、高齡化及數位學習趨勢,生醫領域數位課程融合工研院生醫所以及產學研專家,規劃【精準藥物生產開發及法規實務系列】包含精準醫療、再生醫療細胞治療、生技化粧品生產開發及法規實務、保健食品生產開發及法規實務等課程;以及【智慧醫療器材產品開發應用系列】包含醫學影像判讀、AI醫學影像分析、生醫訊號處理技術與AI演算、醫療器材法規、醫療器材人因工程等課程,加速生醫人才培訓,以滿足整體生醫產業發展所需。
精準醫療檢測產品開發及應用
醫療器材人因工程
保健食品生產開發及法規實務(第14梯)
精準藥物生產開發及法規實務
醫學影像與判讀技術
智慧醫療器材網路安全管理及審查方式(第6梯)
智慧電網與綠能:為培育電力與電網領域的專業人才,集結電力電網領域一級講師群,規劃定置型儲能系統、綠領能源工程師、高功率電力電子等應用課程,協助企業人員在面對智慧電網、儲能、再生能源併網等產業議題,能習得關鍵知識,培育電能即戰力。
依據政府推動產業減碳路徑,企業需先建立碳管理架構,進行碳盤查,設定淨零目標及減碳路徑,並將此資訊納入永續報告書中公開。進一步,企業可採用能源系統優化、低碳技術、循環再生等方法,對碳排放熱點進行有效減碳,並透過碳抵換達成碳中和。產業學院淨零永續數位課程結合最新政策及技術案例(碳管理平台、能源管理、低碳材料等),不僅理論學習,還包含實務案例分析,協助學員學習專業知識,用以制定符合企業特性的減碳策略,實現永續發展目標。
材料高值化與永續研發自學系列:生物質資源
【企業淨零永續】邁向淨零建築:趨勢、法規與實踐
有機化學資源國內外法規趨勢與實務
化學產業淨零轉型與碳管理實務班
污染防治:廢棄物管理及資源循環利用
為培育科技管理領域的跨領域管理人才,集結產學界一級講師群,規劃企業轉型、無形資產評價、智權實務、專利說明書撰寫、資料探勘與專利檢索等數位課程,以接軌國內外企業發展趨勢與就業,培育科技跨域管理人才。
影音專區
《工研院機械技術》破解液櫃晃動難題!下一代AI液冷散熱技術揭密
課程領域
工研院產業學院為產業超前部署未來職缺所需要的關鍵能力,聚焦2030六大關鍵領域技術,讓學習者能提前接軌未來產業需求,成為未來10年搶手人才!